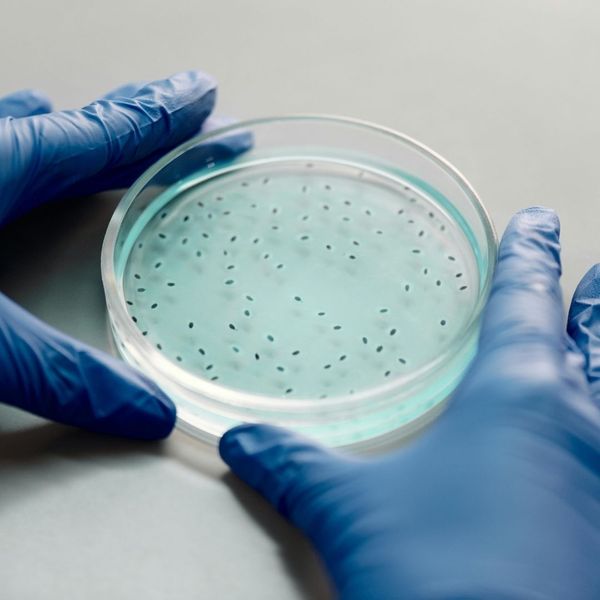

Living off a private well offers independence, but it comes with a silent risk. Unlike city water that is regularly treated and tested, well water can change without warning, hiding contaminants that pose real threats to your family's health and your home’s plumbing. For residents in Brazoria, Richmond, and Edinburg, understanding these hidden dangers is the critical first step in protecting your investment. Home Town Water Filtration is here to help you gain peace of mind through effective whole-house water filtration!
The Hidden Dangers of Contaminated Well Water
Microscopic Invaders: Bacteria, Viruses, and Parasites
Well water can become a host for microbial contaminants, including E. coli, Giardia, and other pathogens that enter from runoff or nearby septic systems. These microscopic invaders can trigger immediate gastrointestinal illnesses like nausea and diarrhea, particularly in young children and the elderly. Regular testing is essential, but a certified whole-house water filtration system is the best, proactive defense against these unseen threats.

The Silent Accumulation: Heavy Metals and Toxic Minerals
Many contaminants are naturally occurring, but no less dangerous. Heavy metals like arsenic, lead, and mercury can leach into your well water from the surrounding soil and rock formations. While they don't cause immediate illness, they accumulate in the body over time, leading to long-term health issues like neurological damage and increased cancer risk.

The Rotten Egg Smell and Red Stains: Iron, Manganese, and Sulfur
Visible water problems like the sulfuric "rotten egg" smell or rust-colored orange/red stains from iron are clear signs of contamination. While often not a health threat, they ruin the taste and odor of your water, stain your clothing and fixtures, and lead to corrosive damage in your plumbing and appliances.

Protecting Your Plumbing: Sediment and Hard Water Damage
Contaminated well water often carries high levels of sediment, grit, and hard water minerals like calcium and magnesium. These particles and minerals cause scale buildup in pipes, drastically reducing water flow and decreasing the lifespan of expensive appliances like water heaters and washing machines.
Schedule Your No-Commitment Consultation
Installing a comprehensive well water filtration system is the only way to ensure truly clean, safe water flows to every tap and appliance in your home. Home Town Water Filtration specializes in custom water systems for the unique needs of Brazoria, Richmond, and Edinburg wells. Get started today!
